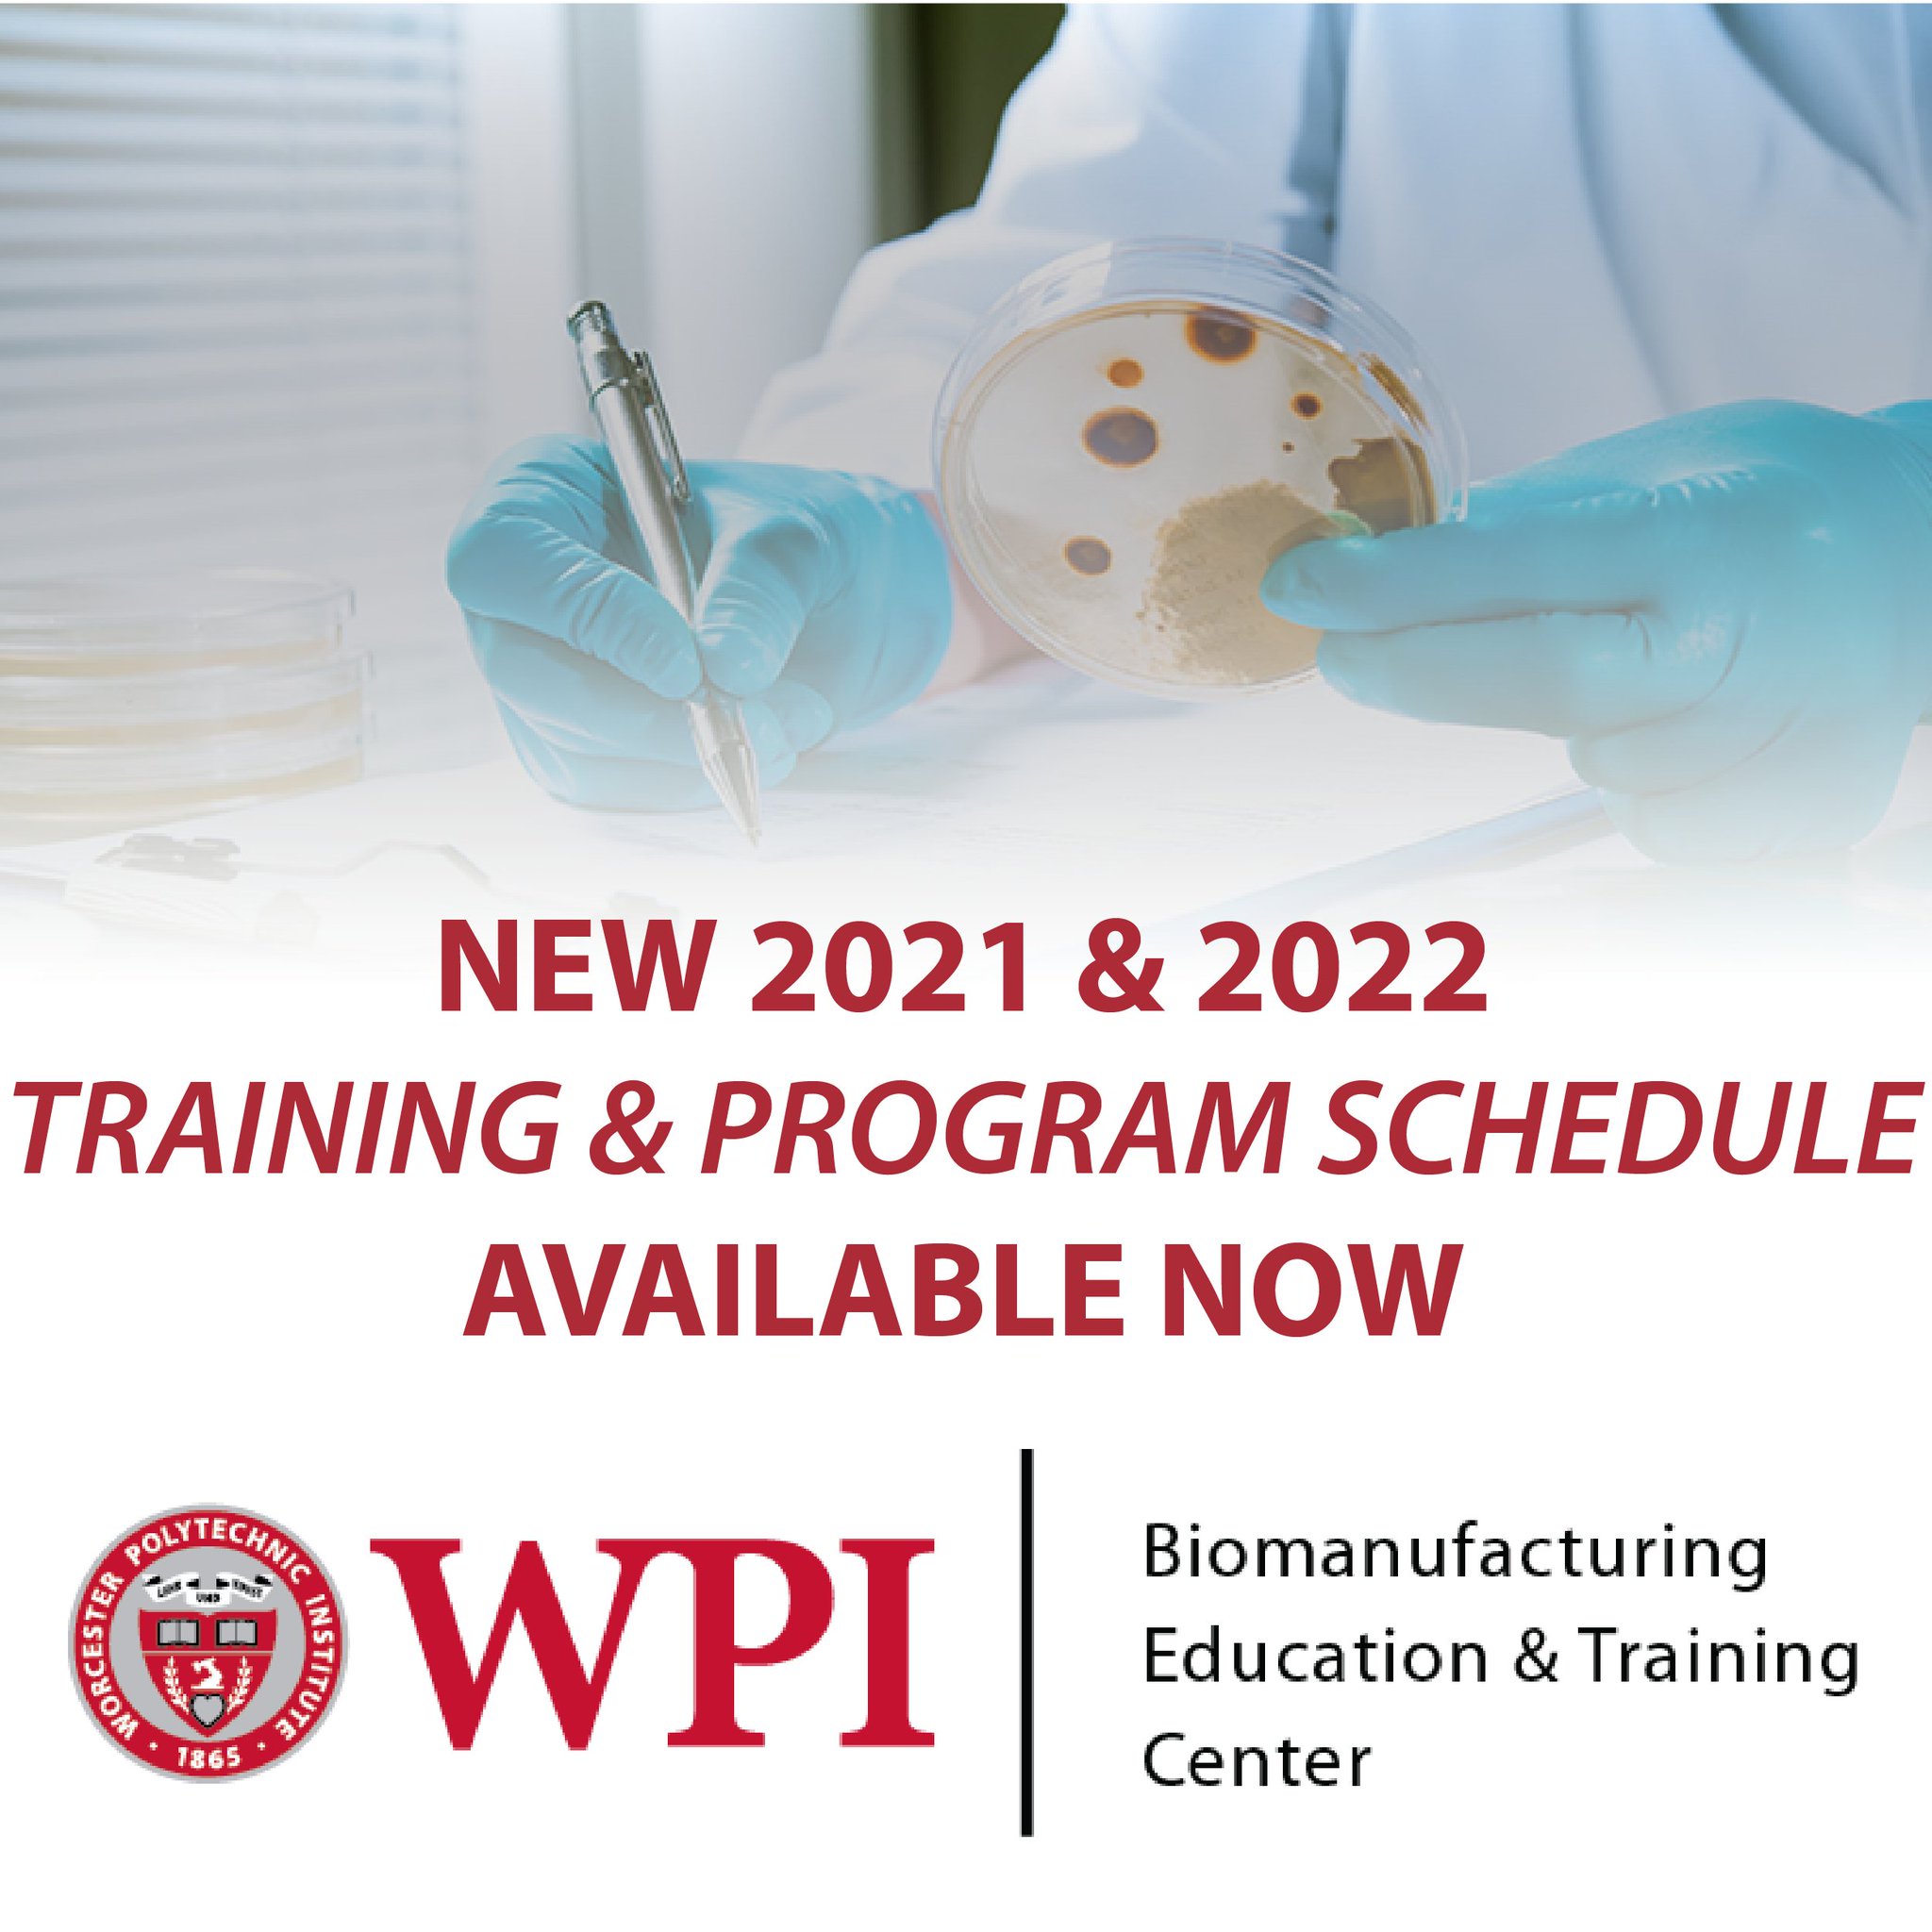

Wpi Course Schedule
Wpi Course Schedule - If you need registration assistance, please see your. Prior to registering, please consult instructions available on the wpi hub. Leading people and effective communication iii (professional officer course) air force aerospace studies. Leading people and effective communication iv. Computer networkingtech coremultiple business tracksassociate degree programs Instead of waiting until the end of the term for student feedback from the course. Course offerings are subject to change. Course registration takes place in workday. Many programs lead to certification and exam fees are often covered. Arranged by individual faculty with special expertise, these courses survey fundamentals in areas that are not covered by the regular aerospace engineering course offerings. A statement of values for undergraduate education at wpi. If you need registration assistance, please see your. We do a lot of things differently at wpi, and that includes our academic schedule. Arranged by individual faculty with special expertise, these courses survey fundamentals in areas that are not covered by the regular aerospace engineering course offerings. Leading people and effective communication iii (professional officer course) air force aerospace studies. Syncs your current schedule and allows you to add and enable/disable combinations of courses in any given term/semester to test possible schedules. The main objective of scope is to enhance teaching at wpi by leveraging the unique perspective of students. Back to online mechanical engineering program page Below are five sample schedules for robotics students. Please note that you cannot take any management courses if you are planning to apply for or accepted into the masters in engineering program. Course offerings are subject to change. Course registration takes place in workday. Some sections of wpi courses may be labeled as “wi” in the course schedules. If you need registration assistance, please see your. The rules, regulations, policies, fees and other charges, courses of study, and academic requirements that appear in this catalog were in. Prior to registering, please consult instructions available on the wpi hub. Some sections of wpi courses may be labeled as “wi” in the course schedules. The rules, regulations, policies, fees and other charges, courses of study, and academic requirements that appear in this catalog were in. We do a lot of things differently at wpi, and that includes our academic. Many programs lead to certification and exam fees are often covered. Start a new job or advance your existing career with online training. Leading people and effective communication iv. Visit wpi.edu/+observances for a list. This is by far the easiest way to build potential schedules,. This is by far the easiest way to build potential schedules,. Back to online mechanical engineering program page Computer networkingtech coremultiple business tracksassociate degree programs Below are five sample schedules for robotics students. Prior to registering, please consult instructions available on the wpi hub. The catalogs are an official publication of wpi. Course offerings are subject to change. This is by far the easiest way to build potential schedules,. Start a new job or advance your existing career with online training. Many programs lead to certification and exam fees are often covered. Many programs lead to certification and exam fees are often covered. Below are five sample schedules for robotics students. A statement of values for undergraduate education at wpi. Computer networkingtech coremultiple business tracksassociate degree programs If you need registration assistance, please see your. The catalogs are an official publication of wpi. Use the guide below to learn more about how our academic calendar is structured. Some sections of wpi courses may be labeled as “wi” in the course schedules. The rules, regulations, policies, fees and other charges, courses of study, and academic requirements that appear in this catalog were in. 10 week courses. Course registration takes place in workday. Course offerings are subject to change. Many programs lead to certification and exam fees are often covered. Use the guide below to learn more about how our academic calendar is structured. Leading people and effective communication iii (professional officer course) air force aerospace studies. We do a lot of things differently at wpi, and that includes our academic schedule. Computer networkingtech coremultiple business tracksassociate degree programs Please note that you cannot take any management courses if you are planning to apply for or accepted into the masters in engineering program. The main objective of scope is to enhance teaching at wpi by leveraging the. The rules, regulations, policies, fees and other charges, courses of study, and academic requirements that appear in this catalog were in. The main objective of scope is to enhance teaching at wpi by leveraging the unique perspective of students. Prior to registering, please consult instructions available on the wpi hub. This is by far the easiest way to build potential. Please note that you cannot take any management courses if you are planning to apply for or accepted into the masters in engineering program. Instead of waiting until the end of the term for student feedback from the course. A statement of values for undergraduate education at wpi. The catalogs are an official publication of wpi. Below are five sample schedules for robotics students. This is by far the easiest way to build potential schedules,. Start a new job or advance your existing career with online training. Leading people and effective communication iv. Arranged by individual faculty with special expertise, these courses survey fundamentals in areas that are not covered by the regular aerospace engineering course offerings. Some sections of wpi courses may be labeled as “wi” in the course schedules. Specify and require standards for ethical writing practices. Syncs your current schedule and allows you to add and enable/disable combinations of courses in any given term/semester to test possible schedules. Course registration takes place in workday. Leading people and effective communication iii (professional officer course) air force aerospace studies. We do a lot of things differently at wpi, and that includes our academic schedule. The main objective of scope is to enhance teaching at wpi by leveraging the unique perspective of students.Northeast UConn September 1517 Engineering Ambassadors
Courses & Core Curriculum Data Science Academics WPI
2016 WPI Softball Schedule Poster on Behance
Good Design at WPI Course Scheduler by Michael Steidel Medium
Good Design at WPI Course Scheduler by Michael Steidel Medium
Good WPI Web Design. Here lies the WPI Schedule Planning… by Zach
Resources & Forms Worcester Polytechnic Institute
Math Tutoring Center (MTC) Mathematical Sciences Departments
Courses & Core Curriculum Data Science Academics WPI
WPI BETC on Twitter "The WPI’s BETC is excited to release our
Course Offerings Are Subject To Change.
Many Programs Lead To Certification And Exam Fees Are Often Covered.
Consult The University Calendar For Specific Dates.
Computer Networkingtech Coremultiple Business Tracksassociate Degree Programs
Related Post:






_Page_1.jpg)
_0.jpg)